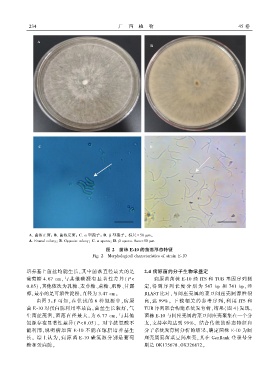

Page 32 - 《广西植物》2025年第2期
P. 32
2 3 4 广 西 植 物 45 卷
A. 菌落正面ꎻ B. 菌落反面ꎻ C. α 型孢子ꎻ D. β 型孢子ꎮ 标尺 = 50 μmꎮ
A. Frontal colonyꎻ B. Opposite colonyꎻ C. α sporesꎻ D. β spores. Bars= 50 μm.
图 2 菌株 E ̄10 的菌落形态特征
Fig. 2 Morphological characteristics of strain E ̄10
培养基上菌丝均能生长ꎬ其中菌落直径最大的是 2.4 病原菌的分子生物学鉴定
葡萄糖 4.67 cmꎬ与其他碳源有显著性差异( P < 病原菌菌株 E ̄10 经 ITS 和 TUB 基因序列测
0.05)ꎬ其他依次为乳糖、麦芽糖、蔗糖、肌醇、甘露 定ꎬ得 到 序 列 长 度 分 别 为 547 bp 和 741 bpꎬ 经
醇ꎬ最小的是可溶性淀粉ꎬ直径为 3.47 cmꎮ BLAST 比对ꎬ与间座壳属的菜豆间座壳同源性很
由图 3:F 可知ꎬ在供试的 6 种氮源中ꎬ病原 高ꎬ达 99%ꎮ 下 载 相 关 的 参 考 序 列ꎬ利 用 ITS 和
菌 E ̄10 对蛋白胨利用率最高ꎬ菌丝生长较好ꎬ气 TUB 序列联合构建系统发育树ꎬ结果( 图 4) 发现ꎬ
生菌丝茂密ꎬ菌落直径最大ꎬ为 6.77 cmꎬ与其他 菌株 E ̄10 与间座壳属的菜豆间座壳聚集在一个分
氮源存在显著性差异( P<0.05) ꎮ 对半胱氨酸不 支ꎬ支持率均达到 99%ꎮ 结合传统的形态特征和
能利用ꎬ说明病原菌 E ̄10 不能在琼脂培养基生 分子系统发育树分析的结果ꎬ确定菌株 E ̄10 为间
长ꎮ 综上认为ꎬ病原菌 E ̄10 碳氮源分别是葡 萄 座壳属真菌菜豆间座壳ꎬ其在 GenBank 登录号分
糖和蛋白胨ꎮ 别是 OK175678、OK326872ꎮ